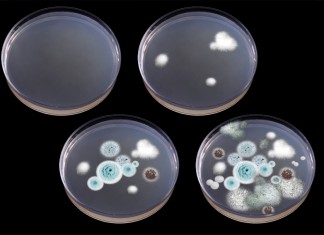
Штативы и другие аксессуары

Нанесение защитной ВУС изоляции на электросварные трубы больших диаметров
Компания «СтальСнаб» производит и реализует трубы больших диаметров. При необходимости на каждую трубу наносится весьма ...
«Лишние» слова: малограмотность или мода?
«Лишние» слова: малограмотность или мода?
Слова-паразиты, или fillers, как их называют в английском, - это лингвистичес...
Ford Cargo — свирепость и мощь
Найти подходящие комплектующие для автомобиля – задача достаточно сложная и в то же самое время довольно интересная. Инт...
Легкость во сне
Мало кто будет спорить о том, что личный комфорт играет существенную роль в жизни каждого современного человека. Однако...
Навыки на дороге важны
Научиться водить автомобиль правильно и уверенно хочет каждый новичок, однако мало кто из них понимает, что все приходит...
Помощь в лестницах!
Выбирать лестницы, для каких бы то ни было целей – ответственное и достаточное неоднозначное дело в плане выбора конкрет...
Переработка идет на пользу
Для всех тех, кто хочет сбыть достаточно много цветных металлов, необходимо, прежде всего, понять, что далеко не всегда ...
Штативы и другие аксессуары
Почти во всех современных лабораториях любого толка можно найти действительно впечатляющие совокупности и комплектующие ...
Хороший выбор техники в сети
Для выбора качественной техники вовсе необязательно обращать внимание исключительно на самые дорогие и на первый взгляд ...
Ремонт — дело ответственное
Ремонт автомобилей – крайне интересное, но в то же время достаточно сложное занятие, которое остается под силу только те...